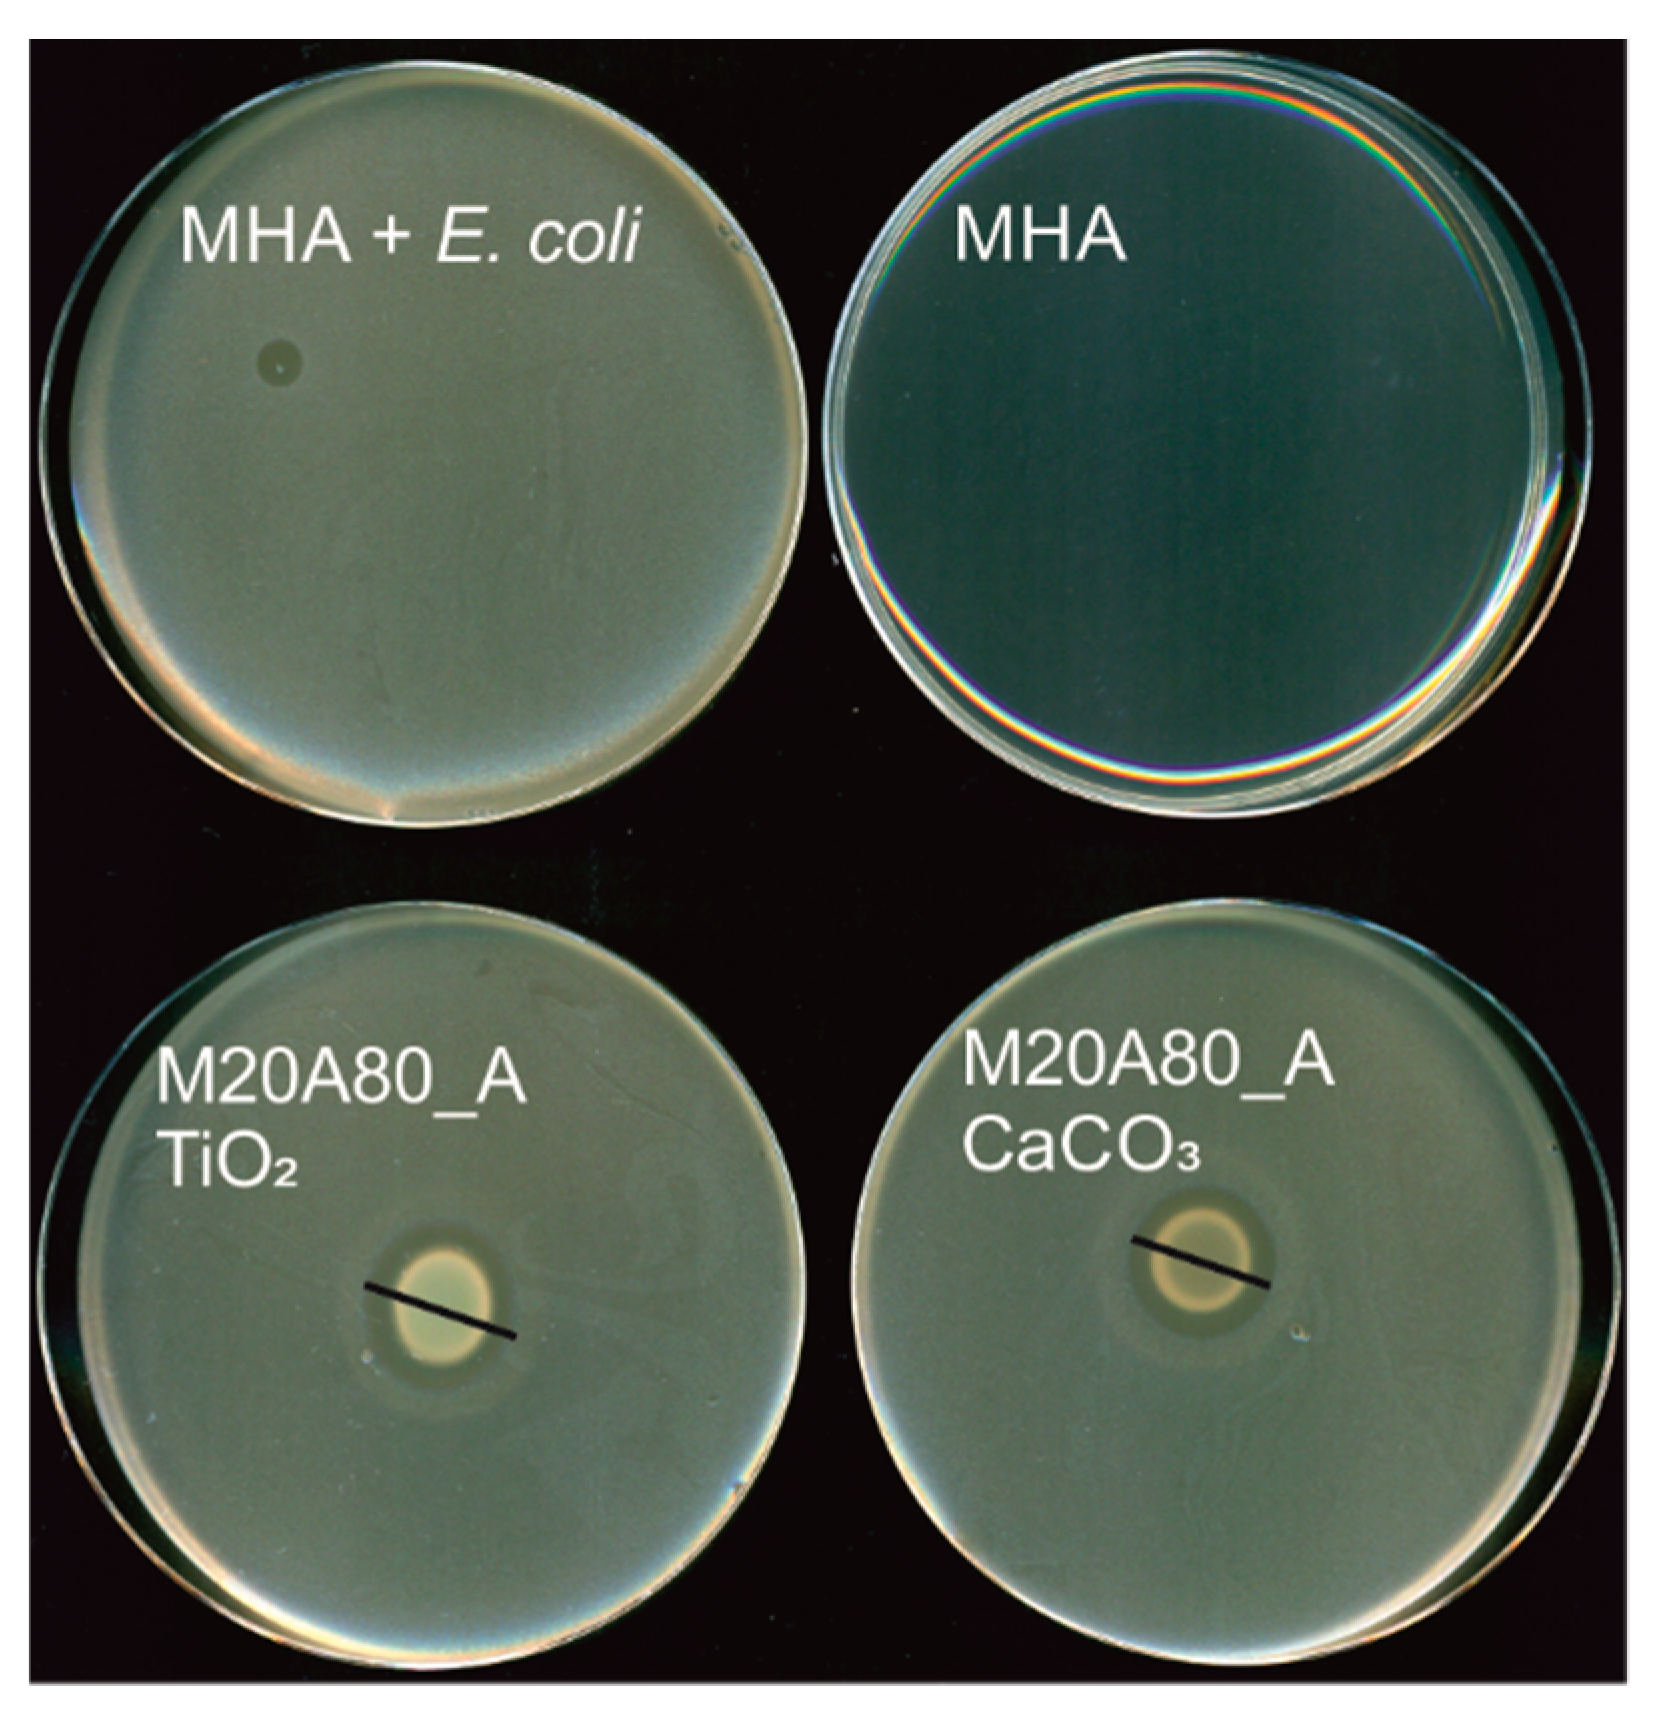
Colloids 03 00020 g003 Colloids 03 00020 g003

Abstract
Increasing antibiotic resistance of several pathogenic microorganisms calls for alternative approaches to prevent spreading of bacterial diseases. We propose to employ for this purpose coatings obtained from positively charged latex dispersions. In this contribution we characterize aqueous mixed dispersions containing TiO2 or CaCO3 and methyl methacrylate-ethyl acrylate or styrene-ethyl acrylate copolymers synthesized using a cationic surfactant, cetyltrimethylammonium bromide as an emulsifier. Particle size, electrokinetic (ζ) potential of the mixed dispersions and the resulting thin films, as well as antimicrobial properties of the latter are described. The TiO2 and CaCO3 dispersions were stabilised with polyethyleneimine (PEI) and optimum pH for the mixed dispersions were chosen on the basis of ζ-potential measurements. For TiO2, the maximum ζ = +35 mV was found at pH 7.5, and for CaCO3, pH was set at 8.2 (ζ = +38 mV), to prevent its dissolution. In most 1:1 mixtures of TiO2 or CaCO3 with the cetyltrimethylammonium bromide (CTAB)-stabilised latex dispersions, two distinct particles populations were observed, corresponding to the bare latex and bare TiO2 or CaCO3 fractions. Films made of the mixed dispersions remained positively charged and showed antimicrobial activity similar or reduced with respect to the bare polymer films.
1. Introduction
Bacterial infections are becoming increasingly difficult to prevent and fight because of a growing number of antibiotic-resistant pathogenic strains. Some areas, like hospitals or nurseries, are especially prone to bacterial infections spreading. One of the most effective ways to prevent them is to apply antibacterial coatings, e.g., in the form of wall paints. Currently, most of the antibacterial coatings of this type rely on antibiotics, triclosan, chlorhexidine, quaternary ammonium compounds or metals (Cu, Ag, Zn) [1].
Natural defence systems of all higher organisms rely on both specific and non-specific mechanisms. While the former involves very complex cascades of biochemical reactions, the non-specific defence system employs relatively simple oligopeptides circulating in the body and available well before the specific immune response is deployed by the organism under attack. The antimicrobial peptides (AMP) are low-molecular weight oligomers accommodating positive charge and a stiff hydrophobic fragment [2]. The two features allow them to bind to negatively charged walls and cytoplasmic membranes of any bacteria. The consequent alteration of the bilayer structure of the membrane may kill both Gram-negative and Gram-positive bacteria. AMP typically consist of 15–20 amino acids with a net charge of at least +2 [3]. Three types of AMP structures, α-helical cathelicidins, β-sheet defensins and kinocidins, dominate in the human defence system [4]. Several types of AMP-mimetic molecules have been synthetized recently [5,6], e.g., phenylene ethynylene oligomers and polymers [7,8], arylamide foldamers [9], arginine-based cationic surfactants [10], aryl-based alkoxyamines [11] or simple quaternary ammonium salts [12,13,14,15,16]. The latter, e.g., cetyltrimethylammonium or tetraethylammonium bromides and cetylpirydinium or benzalkonium chloride, are extensively used in antibacterial and antifungal formulations. Oxyethylated quaternary ammonium salts with C8 to C16 alkyl chains have been introduced into antimicrobial paints based on acrylic polymers at 1 wt % (with respect to the polymer solids). The resulting coatings provided significant activity against several Gram-positive and Gram-negative bacteria, as well as fungi and viruses [17]. The quaternary ammonium salts have also been successfully deposited onto ethylene-vinyl acetate latex in a form of nonstoichiometric complex with polyacrylic acid [18].
Positively charged latexes have been known in the literature for many years. For example, Goodwin et al. reported on synthesis of cationic polystyrene particles in the absence of an added surfactant, with the positive charge impaired solely by the use of cationic initiators [19]. Antonietti et al. employed different combinations of anionic (sodium dodecyl sulfate) and cationic (cetyltrimethylammonium chloride or dodecyltrimethylammonium bromide) surfactants to control the size of polystyrene particles [20]. Nevertheless, most previous studies on cationic polymers obtained with cetyltrimethylammonium bromide (CTAB) and similar tetraalkylammonium salts focused mainly on synthesis and characterisation of the particles [21,22]. The group of Carmona-Ribeiro studied solvent-cast films obtained by spin-coating chloroformic solutions of quaternary ammonium salts with polystyrene and poly(methyl methacrylate). The hybrid films showed antimicrobial activity, especially against S. aureus and E. coli [23,24,25,26]. To the best of our knowledge, however, no study was so far devoted to colloidal stability in the mixed system containing positively charged latex ad inorganic particles in the context of paint formulations. “Classical” paints are based on negatively charged polymeric binders and fillers/pigments stabilised at high pH with water-soluble polymers, e.g., polyacrylates. Reversing the sign of the film-forming latex requires a concomitant reversal of the surface charge of other components, especially the fillers/pigments, to prevent their aggregation due to electrostatic attraction. While some reports exist on synthesis and characterisation of the positively charged latex particles, their films, even in simple systems without inorganic particles, have not been extensively studied so far [27].
In our recent contribution we have described synthesis and characterisation of positively charged methyl methacrylate-ethyl acrylate and styrene-ethyl acrylate copolymers latexes. The positive charge was introduced by employing a cationic surfactant, cetyltrimethylammonium bromide (CTAB) as an emulsifier. The surface charge brought by CTAB was maintained even after extensive dialysis and provided antibacterial activity against Gram-negative (E. coli), Gram-positive (S. aureus, B. subtilis) bacteria and yeast (C. albicans) [28]. In the present contribution we describe an extension of the previous study, by analysing compatibility of the positively charged latexes with two model inorganic particles used as fillers and pigments in real water-borne paints: CaCO3 and TiO2. The former represents a typical filler used extensively in commercial paint formulations, mainly for its very competitive price. The refractive index of CaCO3 is, however, relatively close to that of air (n = 1.7), thus in order to achieve better optical parameters of a paint, TiO2, with n = 2.6, is often added as a pigment to white paints. The main aim of the present study is to verify if colloidal stability and antimicrobial properties of the positively charged latexes could be preserved in the presence of the mineral particles. This will be achieved by preventing heteroaggregation between the small latex particles (of the order of 100 nm) and larger TiO2 and CaCO3 particles (of the order of 1 µm).
2. Materials and Methods
The synthesis and characterisation of methyl methacrylate-ethyl acrylate and styrene-ethyl acrylate copolymers were described in detail in our previous paper [28]. Briefly, all polymers were obtained in an emulsion polymerization process using a cationic surfactant, cetyltrimethylammonium bromide (CTAB) as an emulsifier and either sodium persulphate, Na2S2O8 or (2,2′-azobis(2-methylpropionamidine) dichloride, AAPH, as an initiator (referred to as “anionic” and “cationic”, respectively). For comparison, a methyl methacrylate-ethyl acrylate co-polymer was also prepared using sodium dodecyl sulphate (SDS) as an emulsifier and the “anionic” initiator, in order to obtain a negatively charged latex. The reaction mixtures containing 30% dry mass of polymer solids were dialyzed against Milli-Q water (Millipore, Merck KGaA, Darmstadt, Germany) for 3 days. The efficiency of dialysis was verified by monitoring the electrical conductivity. TiO2 and CaCO3 nanopowders with 21 ± 10 nm and ca. 90 nm diameter, respectively, were purchased from PlasmaChem GmbH (cat. no. PL-TiO-P25 and PL-CACOU). Polyethylenimine (PEI), average Mw ≈ 25000 by LS was purchased from Sigma-Aldrich (cat. no. 408727, Poznań, Poland). Milli-Q water (Millipore, Merck KGaA, Darmstadt, Germany) was used for all experiments. The nanopowders were dispersed in water at 30 g/L using Ultraturrax T25 (10,000 rpm, 15 min, IKA®-Werke GmbH & Co. KG, Staufen, Germany) in the absence or presence of PEI (1% with respect to the polymer solids). pH of the latex and inorganic dispersions was regulated using NaOH and HCl.
2.1. Size and ζ-Potential Measurements
Particle size and ζ-potentials of latex dispersion were measured at 25 °C using a Malvern Zetasizer 3000HS (Malvern Instruments Ltd., Malvern, UK) after a 1000-fold dilution (0.03% dry mass of polymer solids). In calculations of ζ-potential, the classical Helmholtz–Smoluchowski formula was used. Particle sizes are presented as the Sauter mean diameter, D32, defined as follows:
where: Ni is a percentage of the total scattering intensity for a given scattering droplet diameter (di /nm).
ζ-potential measurements for the films prepared from mixed polymeric-inorganic dispersions were performed using a SurPASS Electrokinetic Analyzer equipped with an adjustable gap cell from Anton Paar GmbH (Graz, Austria) by measuring a pressure—streaming current dependency in NaBr solution (10−3 M). For each measurement two pieces of a given polymer film cast on a foil (20 mm × 10 mm) were precisely cut and installed in an adjustable gap cell of the SurPASS instrument (Anton Paar, Graz, Austria), separated with a 100 μm-thick spacer. The foil used as a support was made of poly(ethylene terephthalate) (PET). More details can be found in ref. [28]. The films were spread using a metal bar with 120 μm gap and left to evaporate for 24 h.
2.2. Antimicrobial Testing
The following bacteria: Escherichia coli ATCC8739, Staphylococcus aureus ATCC6538, Bacillus subtilis ATCC6633, Pseudomonas aeruginosa ATCC9027 and yeast Candida albicans ATCC10231 were applied in antimicrobial activity tests. Bacteria were grown in MHB medium (Mueller-Hinton broth, Biocorp, Warsaw, Poland) while yeast in SAB medium (Sabouraud broth, Merck KGaA, Darmstadt, Germany) overnight (about 18 h) at 36 °C ± 1 °C with shaking at 240 rpm (Benchtop shaker SI-600R, LabCompanion, Jeiotech, Daejeon, Korea). Subsequently, the overnight cultures were diluted in fresh media to obtain the required concentration of colony forming units per mL (CFU·mL−1). Antimicrobial tests were performed using the “dry film method” as described in our previous paper [28]. First, the 100 µL portions of each polymer were spotted on the bottom of a sterile Petri dish (Bionovo, Legnica, Poland) and left at room temperature to dry for three days. Then, half of the dried polymer spots placed on the bottom of a Petri dish were washed with a 20 mL portion of sterile Milli-Q water for 15 min at room temperature. After that, the MHA medium (Mueller-Hinton agar, Merck, Germany) inoculated with bacteria (107 CFU·mL−1) or SAB with 2% (w/v) agar inoculated with yeast (106 CFU·mL−1) were poured on the dried polymers. When the media solidified, the Petri dishes were incubated for 20 h at 36 °C ± 1 °C. Thereafter, the growth inhibition zones in solid cultures were visible if the tested polymer was toxic for microbial cells.
3. Results
The synthesis and characterisation of the styrene-acrylic and methacrylic-acrylic copolymers was described in our previous paper [28]. The composition of the copolymers chosen for the present study, determined from the 1H-NMR measurements is shown in Table 1.
Table 1.
Composition of co-polymers employed in the present study (monomer content from 1H-NMR measurements described in [28]).
In the first part of the study, the effect of pH on colloidal stability of individual dispersions of latex and mineral particles was analysed. The latex dispersions were dialysed in order to remove excess CTAB and unreacted monomers and then diluted with Milli-Q water by a factor of 103 for the subsequent measurements of pH dependence of the size and ζ-potential (Figure 1). The Sauter diameter, D32 of all co-polymers showed a rather weak pH dependence in the pH range 3.0–8.5 for all polymers, suggesting their high colloidal stability under the employed experimental conditions. As already noted in our previous study at neutral pH, almost all latex particles obtained with the cationic initiator, AAPH, are 2–3 times smaller than their analogues obtained using the anionic initiator, sodium persulfate. The only exception is the A_100_C and A_100_A couple: the cationic and anionic poly(ethyl acrylate). The ζ-potential measurements confirmed that surface charge of all latexes obtained in presence of CTAB remains positive up to at least pH 8.5. This weak pH dependency is not surprising in view of the fact that the majority of surface charge originates from the presence of the quaternary ammonium cations of CTAB molecules trapped within and adsorbed on the surface of the latex particles. The nature of the initiator used in the synthesis does not play any significant role in determining the ζ(pH) dependency. In the case of analogous co-polymers obtained in presence of an anionic surfactant–sodium dodecyl sulphate (SDS), surface potential is negative, as expected.
Figure 1.
Sauter diameter, D32 (left) and ζ-potential (right) for the polymer dispersions with anionic (top row) and cationic (bottom row) initiator (see Table 1 for compositions).
The wide pH window of colloidal stability of all cationic latex particles renders them good potential candidates for mixing with mineral particles constituting the second major component of most water borne paints—pigments and fillers. In classical paints, because of high pH and the presence of anionic polyelectrolytes (e.g., polycacrylic acid) used as stabilisers, the mineral particles (e.g., TiO2 or CaCO3) are negatively charged. This provides an electrostatic barrier against their coalescence with the negatively charged latex. In the present case of positively charged film-forming co-polymers, the mineral particles should preferably also be positively charged to hinder their heteroaggregation with the latex. In the case of mineral particles, the surface groups can be protonated and deprotonated depending on pH and presence of additional stabilisers. The experimentally determined pH dependencies of Sauter diameter (D32) and ζ-potential for both types of model mineral particles are shown in Figure 2 as filled points. For TiO2, decreasing pH helps to partially disperse the particle aggregates. At pH 3, the size can be reduced to D32 = 600 nm using the applied homogenization procedure, although it should be stressed that this value is still much higher than the primary size of the particles claimed by the supplier (21 ± 10 nm). Electrokinetic measurements confirm that decreasing pH promotes protonation of TiO2 and at pH 3, ζ = +14 mV. As expected, increasing pH reduces the positive surface charge, which favours aggregation manifested in increase of D32. For CaCO3, dissolution in neutral and acidic media limits the pH range of colloidal stability. Nevertheless, even above pH 8 the surface of the employed CaCO3 nanopowder is positively charged (ζ > +20 mV), although the aggregate size remains much above the primary particle limit (1800 nm vs ca. 90 nm).
Figure 2.
Sauter diameter, D32 (left) and ζ-potential (right) for the TiO2 (red squares) and CaCO3 (black circles) dispersions in the absence (closed symbols) and presence of 1% PEI (open symbols). Grey rectangle at high pH corresponds to the region of CaCO3 stability against dissolution.
Both TiO2 (at pH 3) and CaCO3 (at pH > 8) without additional stabilisation are only moderately positively charged. Thus, an effort to increase their ζ-potential was taken by adding a cationic polyelectrolyte, in analogy to the anionic one (poly(acrylic acid)) in “classical” paint formulations containing negatively charged latexes. The addition of 1% polyethyleneimine (PEI) does not change the size(pH) dependency for TiO2 up to pH 7. Surprisingly, above this value the aggregate size increases, despite the reversal of the ζ(pH) dependency. Apparently, increasing pH strengthens the attractive interactions between PEI-covered TiO2 particles. Under these conditions, the adsorbed PEI chains might be heterogeneously protonated, which would result in patches of more and less protonated polymer fragments at different locations of the particle surface. These patches might promote aggregation between the neighbouring PEI-covered particles because of reduced electrostatic repulsion. Consequently, the optimum conditions to prevent aggregation between PEI-covered particles was found at pH 7.5, where ζ-potential is more positive by over 30 mV than in the absence of PEI. In the case of CaCO3, addition of PEI also increased the ζ-potential values within the stability window (pH 8–9) by about 15 mV. As expected, the increase of surface charge helped to reduce the aggregate size of CaCO3 down to about 1100 nm.
Based on the pH dependencies for both latex (Figure 1) and mineral (Figure 2) particles, the optimum conditions to test their compatibility are selected as pH 7.5 for TiO2 and 8.2 for CaCO3, both stabilised with PEI (1% with respect to the polymer solids). Under these conditions, ζ-potential for both particles exceeds +30 mV, which should allow for effective electrostatic stabilisation. For the latex particles, the surface charge at elevated pH is reduced with respect to the acidic and neutral conditions, but still remains positive (ζ > +20 mV). For some polymers (M100A0 and S100A0), the values reaching +40 or even +60 mV are observed at pH > 8.0, but unfortunately their high rigidity (related to the absence of ethyl acrylate monomers) prevents films formation. In view of the potential applications in antimicrobial coatings, they will not be included in the subsequent compatibility study.
In order to test the compatibility of the positively charged latexes and the mineral particles, both dispersions were mixed in 1:1 ratio (dry weight basis), which corresponds to a typical ratio of polymer to fillers/pigments in water-borne paint formulations. The inorganic nanoparticles were first dispersed in aqueous PEI solution at fixed pH (7.5 for TiO2 and 8.2 for CaCO3) and mixed with the following polymer dispersions at the same pH: M20A80_A, S20A80_A, M20A80_C, S20A80_C, A100_A, A100_C and M20A80_A_SDS. The mixtures were left to equilibrate for two days prior to measuring their size and ζ-potential (Table 2). In both mixtures containing the SDS-stabilised polymer dispersion (M20A80_A_SDS) a precipitate was formed at the bottom, pointing to extensive heteroaggregation with CaCO3 and TiO2. In the majority of remaining mixtures two distinct fractions of particles could be observed, one corresponding to the size of latex particles, and one to the size of individual TiO2 or CaCO3 aggregates. For both methacrylate-based latexes (M20A80_A and M20A80_C), only one peak corresponding roughly to the size of the mineral particles can be observed. Although the differences are less pronounced than in the pure latex particle dispersions, when mixed with TiO2 or CaCO3 the anionic latexes are on average smaller than the cationic ones. As in the case of the bare latex dispersions, size distributions of the mixtures containing pure poly(acrylate) polymers are also distinct. The latex-CaCO3 mixtures show very similar and high values of ζ-potential (38 ± 2 mV) independently of the monomer composition and the initiator used. These values are very close to that observed in bare CaCO3. On the other hand, for the latex-TiO2 mixtures, a significant reduction of ζ-potential could be noticed (14 ± 3 mV), with the exception of pure poly(acrylate), where even a slight increase is observed.
Table 2.
Size and ζ-potential values for the mixed dispersions containing cetyltrimethylammonium bromide (CTAB)-stabilised latexes and TiO2 or CaCO3 nanopowders dispersed in 1% PEI (with respect to the polymer solids) at pH 7.5 (TiO2) and 8.2 (CaCO3).
To test the electrokinetic and antimicrobial performance of the cationic polymer-TiO2 and cationic polymer-CaCO3 mixed films, two polymers were selected from the set described above: M20A80_A and S20A80_A. They were chosen based on our previous study of pure polymeric films [28], where both showed good mechanical and antimicrobial properties. For the electrokinetic tests, thin films containing the polymer (M20A80_A or S20A80_A) and mineral particles (TiO2 or CaCO3) in 1:1 ratio (dry solids basis) were cast on a PET foil and fitted into the measuring cell of SurPass analyser. ζ-potential values were calculated from the streaming current measurements recorded by pushing an aqueous electrolyte (10−3 M NaBr) through a thin channel formed by the studied thin films supported on two parallel PET foils. The films containing TiO2 showed similar ζ-potential values of (+24 ± 1 mV for M20A80_A) and (+25 ± 1 mV for S20A80_A), which is close to the values for the bare polymers. Unexpectedly, for CaCO3, the ζ-potential values obtained for the films largely exceeded those measured for the starting dispersions: +82 ± 1 mV for M20A80_A) and (+71 ± 6 mV for S20A80_A).
For antimicrobial tests, the mixed polymer-inorganic films were cast at the bottom of a sterile Petri dish using a pipette (100 μL) and left to dry for 72 h. Half of the spots were rinsed with 20 mL of Milli-Q water in order to rinse off possible water-soluble components (not adsorbed CTAB, PEI, unreacted monomers and/or initiator) [29,30,31,32]. The dried polymer-inorganic films were then covered with the solid media inoculated with the bacteria (P. aeruginosa, E. coli, S. aureus) and fungi (C. albicans). The microbial growth was observed as transparent zones above and around the films. The representative photographs of antimicrobial tests in solid culture media are presented in Figure 3 and the quantitative results are collected in Table 3. The data without TiO2 and CaCO3 from our previous paper [28] are also shown for comparison. In general, the methacrylate derivative (M20A80_A) showed much broader antimicrobial activity than the styrene analogue (S20A80_A). The mixed films of the former show practically the same activity against E. coli as the bare polymer film, although the activity ceases after rinsing with Milli-Q, similar to the case without the mineral particles. Only one composition (M20A80_A with TiO2) showed some activity against P. aeruginosa, but again it disappeared after rinsing with water. For S. aureus, the presence of mineral particles reduces the bacterial growth inhibition zones with respect to the bare M20A80_A and S20A80_A films, although for M20A80_A with TiO2, even after rinsing some antibacterial activity remained. The best results, however, were obtained against the yeast C. albicans, where the antifungal activity of the M20A80_A films containing both CaCO3 and TiO2 remained practically unchanged even after rinsing.
Figure 3.
Representative photographs of antimicrobial tests (against E. coli) in solid culture media. Mueller-Hinton agar (MHA): control plate, MHA + E. coli.: control plate inoculated with E. coli. The black lines indicate the diameters of the zone of growth inhibition.
Table 3.
Bacterial and yeast susceptibility tests in solid culture media. The latexes were spotted on the bottom of empty Petri dish and left to dry, and subsequently covered by solid cultures of microorganisms. The mean (±SD, n = 3) diameters of the zones of growth inhibition are expressed in (mm); nt: not tested.
4. Discussion
Mixed dispersions containing polymer and mineral particles must be stabilised against both homo- and heteroaggregation. According to the Derjaguin–Landau–Vervey–Overbeek (DLVO) theory, the total interaction potential between two particles depends on an interplay between electrostatic and van der Waals interactions [33]. In the case of homoaggregates, formed between the latex or between the mineral particles, the Hamaker constant, H, characterizing the van der Waals contribution, is always positive, leading to attractive interactions between like particles. The latter is especially high for TiO2 (H = 5.35 × 10−20 J) [34], although this value is reduced in most commercially available titania nanopowders by the presence of inorganic coatings (e.g., alumina, with H = 2.75 × 10−20 J) [35] or surface-active stabilisers (e.g., PEI, like in the present case). PEI, in addition to lowering the van der Waals attraction potential, provides positive surface charge manifesting in positive ζ-potential and promoting repulsive electrostatic interactions. Nevertheless, addition of 1% PEI was not sufficient in the present case to fully disperse the secondary aggregates of TiO2. Also, for CaCO3, with Hamaker constant, H = 1.44 × 10−20 J) [34], the effect of PEI was not sufficient to fully disperse the aggregates, despite ζ > +35 mV. On the other hand, a much smaller van der Waals attraction between polymer particles (e.g., for carboxyl-terminated polystyrene latex particles, H = 0.2·× 10−20 J [36] combined with their high positive surface charge (+20 mV < ζ < +67 mV, see Figure 1) resulted in very stable latex dispersions with D32 not showing significant changes in the studied pH range.
In the present case the van der Waals forces between latex and TiO2 or CaCO3 in water are most likely positive and favour their heteroaggregation. The only way to prevent the latter is the maximisation of the repulsive electrostatic interactions between the latex and the TiO2/CaCO3 mineral particles. To this aim, pH of the positively charged mixed dispersions tested in the present study were chosen so that the ζ-potentials of individual dispersions were the highest. Not surprisingly, for the mixture with the SDS-stabilised polymer (M20A80_A_SDS), electrostatic attraction favours heteroaggregation, which resulted in macroscopically observable precipitation. On the other hand, in almost all combinations of CTAB-stabilised latex with CaCO3 (except for A_100_C), the presence of two distinct particle populations with sizes roughly corresponding to the individual components, and the high ζ-potential values, confirm that heteroaggregation can indeed be prevented. Even though for TiO2 the two peak populations are less distinctly pronounced and the ζ-potential values are lower, the lack of macroscopic precipitation suggests that titania does not aggregate with the latexes under the chosen conditions (pH 7.5).
Bare polymeric films made of pure CTAB-stabilised latex dispersions showed moderately positive surface potential values in electrokinetic analysis using streaming potential/current measurements [28]. For the tested set of polymer-inorganic combinations, the nature of the polymer did not affect the electrokinetic characteristics of the mixed films. This is not surprising given the similar ζ-potential values for both bare polymers (M20A80_A and S20A80_A) in the pH range 7.5–8.2 (Figure 1). The presence of TiO2 in the mixed films did not change significantly ζ-potential, in full analogy to the situation in the corresponding mixed dispersions. Unexpectedly, however, both polymers mixed with CaCO3 particles produced highly positively charged films, with ζ-potential higher by ca. 34–44 mV than the corresponding mixed dispersions. Nevertheless, these high values did not translate into increased antimicrobial activity of the films. The TiO2-doped films were in general more efficient than their more positively charged CaCO3-doped counterparts. On the other hand, despite similar electrokinetic characteristics of M20A80_A and S20A80_A, their bare and mineral-doped films showed clearly different antimicrobial behaviour. Most of the mixed films were less active (except for M20A80_A against E. coli) and more susceptible to the activity loss upon rinsing, than their bare polymer analogues. Only antifungal activity of M20A80_A films was improved in presence of both mineral particles—they gained resistance to rinsing with water.
5. Conclusions
In the present contribution we investigated colloidal stability and antimicrobial activity of mixed polymeric-mineral dispersions with positive charge brought by a cationic surfactant (cetyltrimethylammonium bromide, CTAB) and a cationic polymer (polyethyleneimine, PEI). The colloidal stability was analysed at pH 8.2 for CaCO3 and 7.5 for TiO2, chosen on the basis of pH dependency of the size and ζ-potential of the individual (polymeric and mineral) particles. The high positive ζ-potential values for both latex and mineral dispersions at slightly basic conditions prevented their heteroaggregation and allowed to obtain mixed dispersions with separated latex and mineral particle populations. In the absence of electrostatic repulsion, the small latex particles could adsorb on the larger mineral ones, promoting their heteraggregation and eventually leading to macroscopic aggregate formation, as in the case of the negatively charged latex mixed with positively charged mineral particles. The films obtained from the mixed dispersions of CaCO3 and TiO2 with M20A80_A and S20A80_A latexes showed positive ζ-potential values, for CaCO3 reaching up to +82 mV. However, their antimicrobial activity was not improved with respect to their bare-polymer counterparts. Most mixed films lose their activity after rinsing with water, although the presence of both CaCO3 and TiO2 helped to maintain antifungal activity of M20A80_A against C. albicans. The mode of action of quaternary ammonium salts relies on either contact killing or releasing the antimicrobial agents into the neighbourhood. A recent study of Melo et al. [25] showed that CTAB, employed in the present system, is more likely to operate by leaching out from the film to exert its antimicrobial activity. No clear correlation between the magnitude of ζ-potential and antimicrobial activity/selectivity could be derived from the present results. This suggests that the mechanism of antimicrobial activity of the mixed polymer-mineral films is more complex than simple electrostatic interaction.
Author Contributions
Conceptualization, K.W.; methodology, K.W., J.M., P.P; investigation, I.J., M.K., M.G., K.J.; data curation, J.M., K.J., K.W.; writing, K.W.; funding acquisition, K.W.
Funding
This research (including scholarships for I.J. and M.K.) was funded by The National Science Centre (Poland), project “Antimicrobial Polymer Films” (UMO-2015/19/B/ST4/01748) and by Warsaw University of Technology.
Acknowledgments
Agnieszka Borkowska, Marcin Mrowiński and Dominik Gutowski are acknowledged for technical assistance.
Conflicts of Interest
The authors declare no conflict of interest.
References
- Cloutier, M.; Mantovani, D.; Rosei, F. Antibacterial Coatings: Challenges, Perspectives, and Opportunities. Trends Biotechnol. 2015, 33, 637–652. [Google Scholar] [CrossRef] [PubMed]
- Shaik, S. Is my chemical universe localized or delocalized? is there a future for chemical concepts? New J. Chem. 2007, 31, 2015. [Google Scholar] [CrossRef]
- Findlay, B.; Zhanel, G.G.; Schweizer, F. Cationic amphiphiles, a new generation of antimicrobials inspired by the natural antimicrobial peptide scaffold. Antimicrob. Agents Chemother. 2010, 54, 4049–4058. [Google Scholar] [CrossRef] [PubMed]
- Koprivnjak, T.; Peschel, A. Bacterial resistance mechanisms against host defense peptides. Cell. Mol. Life Sci. 2011, 68, 2243–2254. [Google Scholar] [CrossRef]
- Colomer, A.; Pinazo, A.; García, M.T.; Mitjans, M.; Vinardell, M.P.; Infante, M.R.; Martínez, V.; Pérez, L. PH-sensitive surfactants from lysine: Assessment of their cytotoxicity and environmental behavior. Langmuir 2012, 28, 5900–5912. [Google Scholar] [CrossRef] [PubMed]
- Salay, L.C.; Ferreira, M.; Oliveira, O.N.; Nakaie, C.R.; Schreier, S. Headgroup specificity for the interaction of the antimicrobial peptide tritrpticin with phospholipid Langmuir monolayers. Colloids Surf. B Biointerfaces 2012, 100, 95–102. [Google Scholar] [CrossRef] [PubMed]
- Wang, Y.; Chi, E.Y.; Schanze, K.S.; Whitten, D.G. Membrane activity of antimicrobial phenylene ethynylene based polymers and oligomers. Soft Matter 2012, 8, 8547. [Google Scholar] [CrossRef]
- Yang, L.; Gordon, V.D.; Mishra, A.; Som, A.; Purdy, K.R.; Davis, M.A.; Tew, G.N.; Wong, G.C.L. Synthetic antimicrobial oligomers induce a composition-dependent topological transition in membranes. J. Am. Chem. Soc. 2007, 129, 12141–12147. [Google Scholar] [CrossRef]
- Mensa, B.; Kim, Y.H.; Choi, S.; Scott, R.; Caputo, G.A.; DeGrado, W.F. Antibacterial mechanism of action of arylamide foldamers. Antimicrob. Agents Chemother. 2011, 55, 5043–5053. [Google Scholar] [CrossRef]
- Castillo, J.; Pinazo, A.; Carilla, J.; Infante, M.R.; Alsina, M.A.; Haro, I.; Clapés, P. Interaction of antimicrobial arginine-based cationic surfactants with liposomes and lipid monolayers. Langmuir 2004, 20, 3379–3387. [Google Scholar] [CrossRef]
- Thaker, H.D.; Som, A.; Ayaz, F.; Lui, D.; Pan, W.; Scott, R.W.; Anguita, J.; Tew, G.N. Synthetic mimics of antimicrobial peptides with immunomodulatory responses. J. Am. Chem. Soc. 2012, 134, 11088–11091. [Google Scholar] [CrossRef] [PubMed]
- Yu, Q.; Zhang, B.; Ma, F.; Jia, C.; Xiao, C.; Zhang, B.; Xing, L.; Li, M. Novel mechanisms of surfactants against Candida albicans growth and morphogenesis. Chem. Biol. Interact. 2015, 227, 1–6. [Google Scholar] [CrossRef] [PubMed]
- Vieira, D.B.; Carmona-Ribeiro, A.M. Cationic lipids and surfactants as antifungal agents: Mode of action. J. Antimicrob. Chemother. 2006, 58, 760–767. [Google Scholar] [CrossRef] [PubMed]
- Ishikawa, S.; Matsumura, Y.; Katoh-Kubo, K.; Tsuchido, T. Antibacterial activity of surfactants against Escherichia coli cells is influenced by carbon source and anaerobiosis. J. Appl. Microbiol. 2002, 93, 302–309. [Google Scholar] [CrossRef] [PubMed]
- Montazer, M.; Rangchi, F.; Siavoshi, F. Preparation of Protective Disposable Hygiene Fabrics for Medical Applications. In Medical and Healthcare Textiles; Elsevier: New York, NY, USA, 2010; pp. 164–170. ISBN 9781845692247. [Google Scholar]
- Venkata Nancharaiah, Y.; Reddy, G.K.K.; Lalithamanasa, P.; Venugopalan, V.P. The ionic liquid 1-alkyl-3-methylimidazolium demonstrates comparable antimicrobial and antibiofilm behavior to a cationic surfactant. Biofouling 2012, 28, 1141–1149. [Google Scholar] [CrossRef] [PubMed]
- Fulmer, P.A.; Wynne, J.H. Development of broad-spectrum antimicrobial latex paint surfaces employing active amphiphilic compounds. ACS Appl. Mater. Interfaces 2011, 3, 2878–2884. [Google Scholar] [CrossRef]
- Makarewicz, E.N.; Shiichuk, A.V.; Syrotyns’ka, I.D. Quaternary ammonium salts as antimicrobial additives to water-dispersible paints. Russ. J. Appl. Chem. 2011, 84, 888–891. [Google Scholar] [CrossRef]
- Goodwin, J.W.; Ottewill, R.H.; Pelton, R. Studies on the preparation and characterization of monodisperse polystyrene latices V.: The preparation of cationic latices. Colloid Polym. Sci. 1979, 257, 61–69. [Google Scholar] [CrossRef]
- Antonietti, M.; Lohmann, S.; Van Niel, C. Polymerization in microemulsion. 2. Surface control and functionalization of microparticles. Macromolecules 1992, 25, 1139–1143. [Google Scholar] [CrossRef]
- Kong, X.Z.; Zhu, X.; Jiang, X.; Li, X. Preparation and full characterization of cationic latex of styrene–butyl acrylate. Polymer 2009, 50, 4220–4227. [Google Scholar] [CrossRef]
- Liu, Z.; Xiao, H.; Wiseman, N. Emulsifier-free emulsion copolymerization of styrene with quaternary ammonium cationic monomers. J. Appl. Polym. Sci. 2000, 76, 1129–1140. [Google Scholar] [CrossRef]
- Naves, A.F.; Palombo, R.R.; Carrasco, L.D.M.; Carmona-Ribeiro, A.M. Antimicrobial Particles from Emulsion Polymerization of Methyl Methacrylate in the Presence of Quaternary Ammonium Surfactants. Langmuir 2013, 29, 9677–9684. [Google Scholar] [CrossRef] [PubMed]
- Sanches, L.M.; Petri, D.F.S.; de Melo Carrasco, L.D.; Carmona-Ribeiro, A.M. The antimicrobial activity of free and immobilized poly (diallyldimethylammonium) chloride in nanoparticles of poly (methylmethacrylate). J. Nanobiotechnol. 2015, 13, 58. [Google Scholar] [CrossRef] [PubMed]
- Melo, L.D.; Palombo, R.R.; Petri, D.F.S.; Bruns, M.; Pereira, E.M.A.; Carmona-Ribeiro, A.M. Structure–Activity Relationship for Quaternary Ammonium Compounds Hybridized with Poly(methyl methacrylate). ACS Appl. Mater. Interfaces 2011, 3, 1933–1939. [Google Scholar] [CrossRef] [PubMed]
- Pereira, E.M.A.; Kosaka, P.M.; Rosa, H.; Vieira, D.B.; Kawano, Y.; Petri, D.F.S.; Carmona-Ribeiro, A.M. Hybrid Materials from Intermolecular Associations between Cationic Lipid and Polymers. J. Phys. Chem. B 2008, 112, 9301–9310. [Google Scholar] [CrossRef]
- Ramos, J.; Forcada, J.; Hidalgo-Alvarez, R. Cationic Polymer Nanoparticles and Nanogels: From Synthesis to Biotechnological Applications. Chem. Rev. 2014, 114, 367–428. [Google Scholar] [CrossRef]
- Wojciechowski, K.; Kaczorowski, M.; Mierzejewska, J.; Parzuchowski, P. Antimicrobial dispersions and films from positively charged styrene and acrylic copolymers. Colloids Surf. B Biointerfaces 2018, 172, 532–540. [Google Scholar] [CrossRef]
- Van der Kooij, H.M.; Sprakel, J. Watching paint dry; more exciting than it seems. Soft Matter 2015, 11, 6353–6359. [Google Scholar] [CrossRef]
- Steward, P.A.; Hearn, J.; Wilkinson, M.C. An overview of polymer latex film formation and properties. Adv. Colloid Interface Sci. 2000, 195–267. [Google Scholar] [CrossRef]
- Kiil, S. Drying of latex films and coatings: Reconsidering the fundamental mechanisms. Prog. Org. Coat. 2006, 57, 236–250. [Google Scholar] [CrossRef]
- Keddie, J.L. Film formation of latex. Mater. Sci. Eng. R Rep. 1997, 21, 101–170. [Google Scholar] [CrossRef]
- Lyklema, J. Surface charges and electrokinetic charges: Distinctions and juxtapositionings. Colloids Surf. A Physicochem. Eng. Asp. 2011, 376, 2–8. [Google Scholar] [CrossRef]
- Bergström, L. Hamaker constants of inorganic materials. Adv. Colloid Interface Sci. 1997, 70, 125–169. [Google Scholar] [CrossRef]
- Farrokhpay, S. A review of polymeric dispersant stabilisation of titania pigment. Adv. Colloid Interface Sci. 2009, 151, 24–32. [Google Scholar] [CrossRef] [PubMed]
- Elzbieciak-Wodka, M.; Popescu, M.N.; Ruiz-Cabello, F.J.M.; Trefalt, G.; Maroni, P.; Borkovec, M. Measurements of dispersion forces between colloidal latex particles with the atomic force microscope and comparison with Lifshitz theory. J. Chem. Phys. 2014, 140, 104906. [Google Scholar] [CrossRef] [PubMed]
© 2019 by the authors. Licensee MDPI, Basel, Switzerland. This article is an open access article distributed under the terms and conditions of the Creative Commons Attribution (CC BY) license (http://creativecommons.org/licenses/by/4.0/).